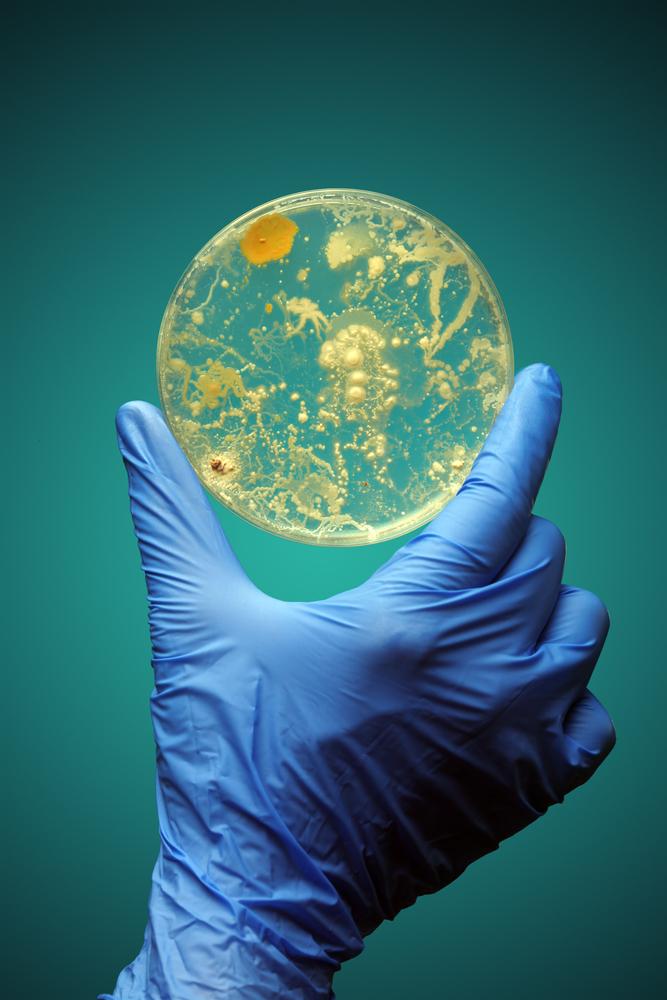

Откриха над 12 000 нови вида микроби
Искате да си отгледате микроби в петриева паничка? Елементарно е. Вземете секрет от каквото си пожелаете с най-обикновена клечка за уши, натъркайте я върху стъкло с агар, оставете го да престои няколко дни в топла стая и готово! Вие току-що си отгледахте нови космати приятелчета.
Микробните видове обаче, които може да култивирате в петриева паничка, са само малка част от бактериите, археите и останалите микроорганизми, които сте грабнали заедно с клечката за уши – това са просто онези, които са подходящи за условията, в които сте ги отгледали.
По-голямата част от организмите просто не харесват средата, която можем да им предложим, и съответно не биха процъфтели в петриева паничка.
Сега международен екип от изследователи използва нова техника, наречена метагеномика, и откри 12 556 нови вида бактерии и археи, които никога досега не са били отглеждани в лабораторни условия.
„Успяхме да реконструираме хиляди метагеномно асемблирани геноми (МАГ) директно от секвенираните проби – без необходимостта да култивираме микробите в лабораторията – казва генетикът и водещият автор на проучването Стивън Нейфах от Съвместният геномен институт на Министерството на енергетиката на САЩ. – Това, с което настоящото изследване изпъква над предишните подобни начинания, е забележителното разнообразие на анализираните проби.“
Карта на местата и типовете МАГ, които са били секвенирани. Източник: Nayfach et al., Nature Biotechnology, 2020
Екипът е имал достъп до огромна база данни с над 10 000 метагеномна – термин, обединяващ целия генетичен материал от една проба. Всяка една ДНК, която могат да извлекат, се секвенира с помощта на миниатюрни геномни нишки. След това те се опитват да сглобят отново тези къси парченца ДНК.
Представете си, че слагате пъзел в блендер, след което се опитвате да го подредите, и няма да сте далече от истината. С помощта на тази техника обаче екипът успява да сглоби 52 515 МАГ от тези данни – много от тях с високо качество. Нещо повече - геномът на всички е с над 50 процента завършеност.
Това не е първият екип, който използва мегеномика, за да открие микроби. През 2018-а учени откриха 16 гигантски вируса, а с помощта на тези методи през 2017-а изследователи се натъкнаха на 20 нови еволюционни клона в дървото на живота.
В този нов труд обаче изследователите са се опитвали да анализират проби от най-разнообразни места (океани и друго морски райони, местности, обитавани от хора и животни, както и почви и други земни среди), за да разширят познанията ни за микробите.
Изследването е публикувано в Nature Biotechnology.